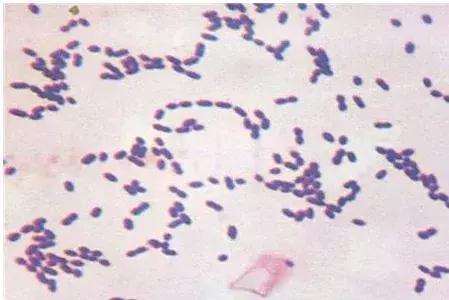
你正用的枕头是腰痛、脑梗的元凶？家有这种枕头的，抓紧时间换掉

人的一生,有三分之一的时间都是在睡眠中度过的,可真正睡得好的人寥寥无几。
很多人睡完觉不仅没有觉得放松,反而觉得更累!而且睡觉前,老半天睡不着,即使睡着了也总是睡不安稳,半夜还经常做噩梦,早上天还没亮又醒了......

有人不禁感叹:“想睡个好觉,怎么那么难!”
其实,那是你没有找对方法。想想看,睡觉的时候,陪着你最久的是谁?不是你的伴侣,是你的枕头!
【你绝对想不到的,腰痛、脑梗元凶竟是它!】
很少有人知道,脑血栓的源头竟在心脏上!
血栓由不溶性纤维蛋白、沉积的血小板、积聚的白细胞、陷入的红细胞组成,极可能威胁生命。那为什么心脏的血栓会跑到大脑呢?

正常人的心脏就像拳头大小,但一些疾病会导致心脏扩大。正常心脏的心耳,是一个非常光滑的腔,但病变的心脏,其心耳里会形成血栓。

左心耳和左心房是心脏的一个蓄水池,心房里的血液会排到心室。
当心耳里有血栓时,可能会长期潜伏在心脏中,一旦脱落,80%的血栓会快速跑到大脑,从而诱发脑梗。剩余的20%会跑到全身的其他部位,引起栓塞,危害极大!
链球菌,可以分布在很多地方,会增加血栓风险。有些血栓可以在短短几个小时内形成,速度非常快,一般房颤48小时以上,左心房就会形成血栓。但每个人情况不一样,有些人也可能好几年都不长血栓。
很少有人知道:枕头使用时间越长,滋生链球菌的可能就越大,心脏长血栓的风险也越大!

枕头不好,除了会引发脑梗,还会引发腰痛!平时,总有很多人经常会觉得腰痛,但很难找到病因!
长期平躺,会导致内脏挤压脊椎、肌肉,肌肉长期受压后会产生乳酸堆积,导致腰痛。
趴卧时,肌肉虽然松快了,但整个身体的重量都会压在内脏上,也不健康。最标准的睡姿是右侧卧位睡姿,可缓解腰痛症状。
睡觉时正常翻身,可以保护腰椎。通常情况下,一个人每晚平均要翻身20次左右。如果睡觉时翻身少,会造成不同程度的腰痛。
有9成人都不知道:枕头的高低也会影响翻身次数!只有在侧卧位时,额头、鼻尖、下巴、胸骨处于一条线上,才是适合您的枕头。
【家里有这种枕头,抓紧时间换掉!】
1、枕头太高
我国有个成语叫:“高枕无忧”,但高枕真的是无忧吗?
事实并非如此!人体的脊柱不是完全笔直的,而是有一定的弯曲度,颈部弯曲的地方称为“颈曲”,好的枕头应该与人体颈部曲线完美贴合。
如果枕头太高,人睡觉时就处于低头的姿势,这和一整夜低头玩手机没什么两样!对颈椎都有很大的伤害。

2、枕头太低
除了高枕头以外,还有很多人喜欢睡低枕头,甚至是睡觉不用枕头。如果长期枕低枕头或者不枕枕头,会让人被动处于仰头的状态,长期这样脖子能不累吗?
不仅如此,太低的枕头,还会让呼吸系统受到影响,出现张嘴呼吸、打鼾等问题。
3、枕头太短
还有的人枕头高度合适,但又太短。谁能保证睡觉时很老实,一直枕在同样的地方不动呢?如果枕头太短太窄,稍微翻个身,就和床来了个亲密接触,又变成了仰头的姿势。
本文来源 安徽卫视《健康大问诊》,部分图片来源网络,如图片侵权,请及时联系我们删除,谢谢